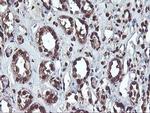
OSGEP Antibody in Immunohistochemistry (Paraffin) (IHC (P))

Search
Invitrogen
OSGEP Monoclonal Antibody (OTI9E3)
{{$productOrderCtrl.translations['antibody.pdp.commerceCard.promotion.promotions']}}
{{$productOrderCtrl.translations['antibody.pdp.commerceCard.promotion.viewpromo']}}
{{$productOrderCtrl.translations['antibody.pdp.commerceCard.promotion.promocode']}}: {{promo.promoCode}} {{promo.promoTitle}} {{promo.promoDescription}}. {{$productOrderCtrl.translations['antibody.pdp.commerceCard.promotion.learnmore']}}
图: 1 / 8
OSGEP Antibody (MA5-25567) in IHC (P)

Please note: We are reviewing Western blot images included in the antibody testing data in our catalog, including those provided by third parties. Unless expressly labeled or annotated as “raw-unedited”, Western blot images included in the antibody testing data in our catalog may have been edited, optimized or otherwise adjusted for presentation.
产品信息
MA5-25567
种属反应
宿主/亚型
分类
类型
克隆号
抗原
偶联物
形式
浓度
规格
纯化类型
保存液
内含物
保存条件
运输条件
RRID
靶标信息
Osgep (O-sialoglycoprotein endopeptidase), also known as GCPL1, is a 335 amino acid protein that is a member of the peptidase M22 family. Osgep specifically cleaves the 31-Arg-l-Asp-32 bond in glycophorin A, but it does not cleave desialylated glycoproteins, unglycosylated proteins or glycoproteins that are only N-glycosylated. Though ubiquitously expressed at low levels, highest levels of Osgep are found in liver, skeletal muscle and kidney. OSGEPL1, also known as Qri7, is a 414 amino acid protein that belongs to the KAE1/YgjD family and exists as three alternatively spliced isoforms. In tRNAs that have codons beginning with adenine, OSGEPL1 is required for the formation of a threonylcarbamoyl group on adenosine.
仅用于科研。不用于诊断过程。未经明确授权不得转售。
篇参考文献 (0)
生物信息学
蛋白别名: hOSGEP; mOsgep; N6-L-threonylcarbamoyladenine synthase; O-sialoglycoprotease; O-sialoglycoprotein endopeptidase; O-sialoglycoprotein endopeptidase {ECO:0000255|HAMAP-Rule:MF_03180}; pasteurella haemolytica metalloprotease homolog with glycoprotein substrates/gpc-like protein 1; probable O-sialoglycoprotein endopeptidase; probable tRNA N6-adenosine threonylcarbamoyltransferase; probable tRNA N6-adenosine threonylcarbamoyltransferase {ECO:0000255|HAMAP-Rule:MF_03180}; probable tRNA threonylcarbamoyladenosine biosynthesis protein Osgep; Prsmg1/Gcpl1; t(6)A synthase; t(6)A37 threonylcarbamoyladenosine biosynthesis protein OSGEP; t(6)A37 threonylcarbamoyladenosine biosynthesis protein Osgep {ECO:0000255|HAMAP-Rule:MF_03180}; tRNA N6-adenosine threonylcarbamoyltransferase; tRNA threonylcarbamoyladenosine biosynthesis protein OSGEP; tRNA threonylcarbamoyladenosine biosynthesis protein Osgep {ECO:0000255|HAMAP-Rule:MF_03180}
基因别名: 1500019L24Rik; GCPL-1; GCPL1; OSGEP; PRSMG1
UniProt ID: (Rat) Q9WVS2, (Mouse) Q8BWU5
Entrez Gene ID: (Dog) 100687555, (Rat) 290028, (Mouse) 66246




